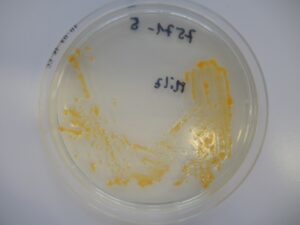
Flavobacterium psychrophilum

Herzlich Willkommen
… auf der Homepage der hessischen Erwerbsfischer, Fischzüchter und Teichwirte.
Die hessischen Erwerbsfischer sind organisiert im VHF, dem Verband Hessischer Fischer e.V., dessen Wurzeln auf die erste Vereinigung von Fischzüchtern in Hessen aus dem Jahre 1878 zurückgehen. Unser Berufsstand ist in verschiedene Bereiche spezialisiert.
Fluss- und Seenfischerei sowie Teichwirtschaft sind zwei davon, geographisch bedingt steht die Fischzucht von Forellen in unserem Bundesland an erster Stelle.
Die in unserem Verband organisierten Betriebe sind zuverlässige Lieferanten von unterschiedlichsten Fischarten und bieten diese Fische in einem breit gefächerten Programm an. Mit dieser Internetpräsenz möchten wir uns vorstellen und Ihnen gleichzeitig die Möglichkeit bieten, aus einem umfassenden Angebot unserer Mitglieder Ihre Auswahl zu treffen!
Wenn Sie weitere Fragen zu unserem Berufsstand haben, freuen wir uns, von Ihnen zu hören!
Vorteile als Mitglied
Die hessischen Fischzüchter stellen sich vor.
Unsere Website ist der ideale Ort, um mehr über die hessische Fischwirtschaft zu erfahren, unsere Mitglieder kennenzulernen und Ihre Fischbestellungen bequem online aufzugeben. Wir heißen Sie herzlich willkommen und freuen uns darauf, Sie mit frischem und schmackhaftem Fisch aus Hessen zu versorgen. Ganz gleich, ob Sie ein Restaurantbetreiber, Einzelhändler oder Liebhaber von Qualitätsfisch sind - beim Verband Hessischer Fischer e.V. sind Sie genau richtig!
Über uns
Unser Berufsstand
Unsere Mitglieder
Unsere Mission
Entdecken Sie mehr
Hier erfahren Sie mehr über spannende Themen.
Kontakt
Wir freuen uns darauf, von Ihnen zu hören und Ihre Anliegen zu besprechen.